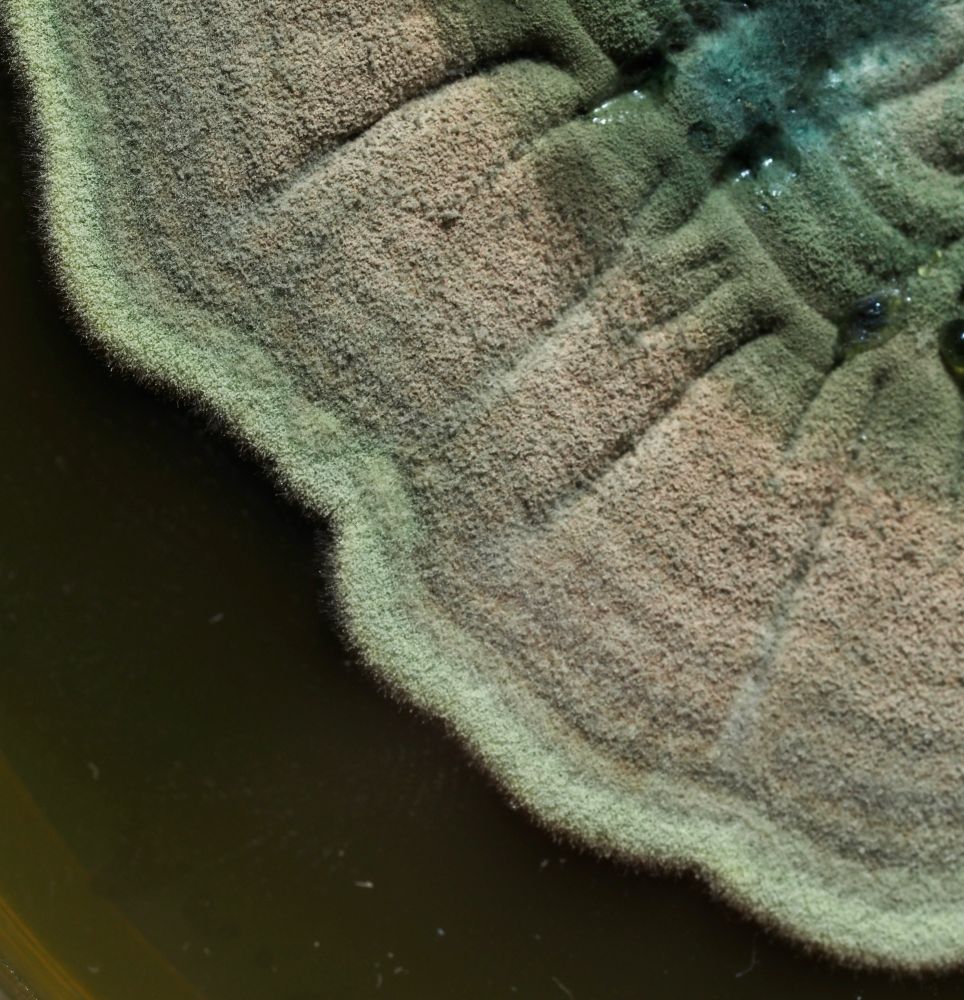
Post image

Had the pleasure of hearing from @maxkozlov.bsky.social today here at UFGI about his transition from a Ph.D. to becoming a science journalist at Nature.
Great insight into how important communication is to disseminating our ideas to colleagues and the public, especially now.
Thank you, Max!
28.03.2025 16:36 — 👍 1 🔁 0 💬 0 📌 0

3 paperback books stacked in a pyramid. The three books are William Gibson’s Neuromancer, The Wall Between by Anne Braden, and Roots of Rebellion by Richard P. Young
Whenever I go to an unfamiliar city I always look for the small used bookstores. Cozy, comfortable, and filled with treasure.
22.02.2025 17:55 — 👍 4 🔁 0 💬 0 📌 0
The entire archive of CDC datasets can be found here.
HUGE shoutout to data archivists- this work is important 👏🙌🏻
archive.org/details/2025...
01.02.2025 18:33 — 👍 11868 🔁 4694 💬 226 📌 224

🚨 If you haven’t seen it yet…
📢 The NIH BioArt Source provides a library of FREE professionally designed illustrations and icons, available for anyone to use. They can be Downloaded in High Definition.
Check it out at bioart.niaid.nih.gov
23.11.2024 23:30 — 👍 154 🔁 58 💬 5 📌 4

Hello, Bluesky!
I’m Ron, a second year Ph.D. Student at the University of Florida. I have a keen interest in #syntheticbiology, #controlsystems, and #biomanufacturing.
Outside of academics, my posse (shown below) and I love to be in the outdoors hiking, camping, and taking photos. 😎🧪
22.11.2024 20:14 — 👍 6 🔁 0 💬 1 📌 0

The Influence of Bell Labs
We’ve talked previously about Bell Labs’ long, storied history as an innovation engine and a generator of new technology.
"As in a conventional academic lab, scientists had the freedom to pursue research avenues they found promising without being bound by concerns of immediate profitability or return on investment."
There are lessons here to take to heart about progress.
www.construction-physics.com/p/the-influe...
18.11.2024 23:43 — 👍 29 🔁 7 💬 2 📌 2
Biomedical Engineering PhD Student at Georgia Tech
Studying metabolic evolution, microbial macroevolution, biospheric self-organization, and the feedbacks between Earth and life. Dad, Husband, Scientist.
https://rogierbraakman.com/
Eleftheria Anastasia Beres
PhD Student @uwcse.bsky.social
she/her/hers
http://eleft.asia
Find The Best Bargains In Vinyl!
Please note that deals may & do expire after post. As an Amazon Associate I earn from qualifying purchases. Thanks for following!
Assistant Professor at UT Southwestern Medical Center | Full-time reproductive biologist | Part-time genomics technology developer | Lab website: https://haiqichenlab.github.io/
Research Assistant Professor of Biochemistry and Biophysics | Director, Johnson Foundation Biophysics and Structural Biology Core Facility | Univ of PA | he/him
Delivered effective, efficient, and secure digital services for the American people until we were forced to stop on March 1, 2025. Not an official government account. Reposts are not endorsements. Our new website: https://18f.org/ #AltGov
Harvard and SBU Alumnus | Emo nerd still living in 2006 | Molecular Biologist in Industry 🧬
Associate Professor at the University of Parma | Laboratory of Bioartificial Systems and Biosensors | Head of www.bertuccilab.com 🇪🇺 DNA Nanotechnology, Hybrid Bionanomaterials and all CRISPR things
Microbes & mucus 🤩 | Gut Microbial Ecology | Wageningen University, NL
Science Education | Undergrad Research |Microbio/Phage/Viruses| 🧬🎸🚵 ⚽️📚
Lecturer in Microbial Biotechnology and Bioinformatics at the School of Pharmacy, Queen's University Belfast. #Phage, microbes, genomes, computers.
Host of Hardcore History. I do other stuff too. Find our (free) irregularity updated newsletter at https://dancarlin.substack.com
Website: www.dancarlin.com
Retired optometrist enjoying reading,
sci fi ,thrillers and best sellers ,traveling and
golfing with my wonderful wife.
Bluesky is the resistance!
Political scientist University of South Carolina. Interests: business politics/corruption, Middle East, measurement, Bayesian statistics
The Bayesian Hitman: https://a.co/d/e4QmtKo
Website: www.robertkubinec.com
Teacher, researcher, globalist, republican.
tompepinsky.com
policy, $, political economy of race // 70-80s soul, 90s hip hop // #DubNation // proud product of miscegenation // Berkeley prof (formerly: Princeton CSDP, UW)
Assistant Professor at American University
Nonresident Senior Fellow at Brookings
Me: https://sharangrewal.com/
My book: https://www.amazon.com/Soldiers-Democracy-Military-Legacies-Spring/dp/0198873514/
Political science professor. Has thoughts about that thing someone said.
Book: Backlash Presidents: From Transformative to Reactionary Leaders in American History
https://tinyurl.com/te8cmzmr
https://goodpoliticsbadpolitics.substack.com/
i write the data-driven politics newsletter Strength In Numbers: gelliottmorris.com/subscribe
wrote a book by the same name wwnorton.com/books/Strength-in-Numbers
polling averages at @fiftyplusone.news
formerly @ 538 & The Economist. email, don't DM, me